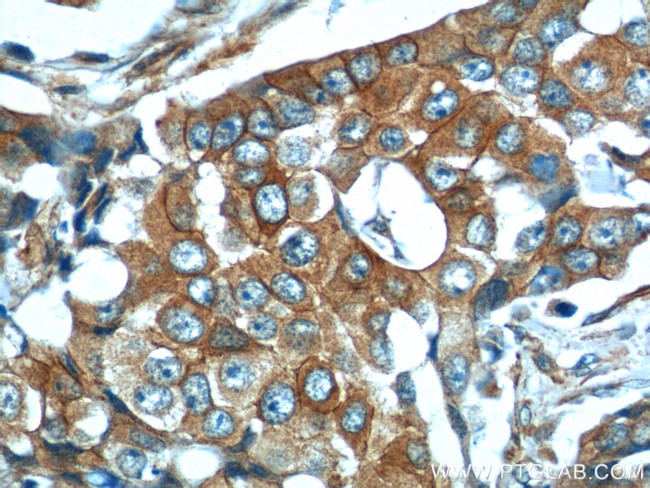
CDH26 Antibody in Immunohistochemistry (Paraffin) (IHC (P))

Search
Proteintech
CDH26 Polyclonal Antibody
{{$productOrderCtrl.translations['antibody.pdp.commerceCard.promotion.promotions']}}
{{$productOrderCtrl.translations['antibody.pdp.commerceCard.promotion.viewpromo']}}
{{$productOrderCtrl.translations['antibody.pdp.commerceCard.promotion.promocode']}}: {{promo.promoCode}} {{promo.promoTitle}} {{promo.promoDescription}}. {{$productOrderCtrl.translations['antibody.pdp.commerceCard.promotion.learnmore']}}
产品信息
20057-1-AP
种属反应
已发表种属
宿主/亚型
分类
类型
抗原
偶联物
形式
浓度
规格
纯化类型
保存液
内含物
保存条件
运输条件
产品详细信息
This antibody can recognize all the isoforms of CDH26.
靶标信息
Cadherins are a family of adhesion molecules that mediate Ca2+-dependent cell-cell adhesion in all solid tissues and modulate a wide variety of processes, including cell polarization and migration. Cadherin domains occur as repeats in the extracellular region and are thought to contribute to the sorting of heterogeneous cell types and the maintenance of orderly structures such as epithelium. This gene encodes a cadherin domain-containing protein whose specific function has not yet been determined. Alternative splicing occurs at this locus and two transcript variants, encoding distinct proteins, have been identified.
仅用于科研。不用于诊断过程。未经明确授权不得转售。
生物信息学
蛋白别名: Cadherin; cadherin-like 26; Cadherin-like protein 26; Cadherin-like protein VR20; unnamed protein product
基因别名: CDH26; VR20
UniProt ID: (Human) Q8IXH8
Entrez Gene ID: (Human) 60437